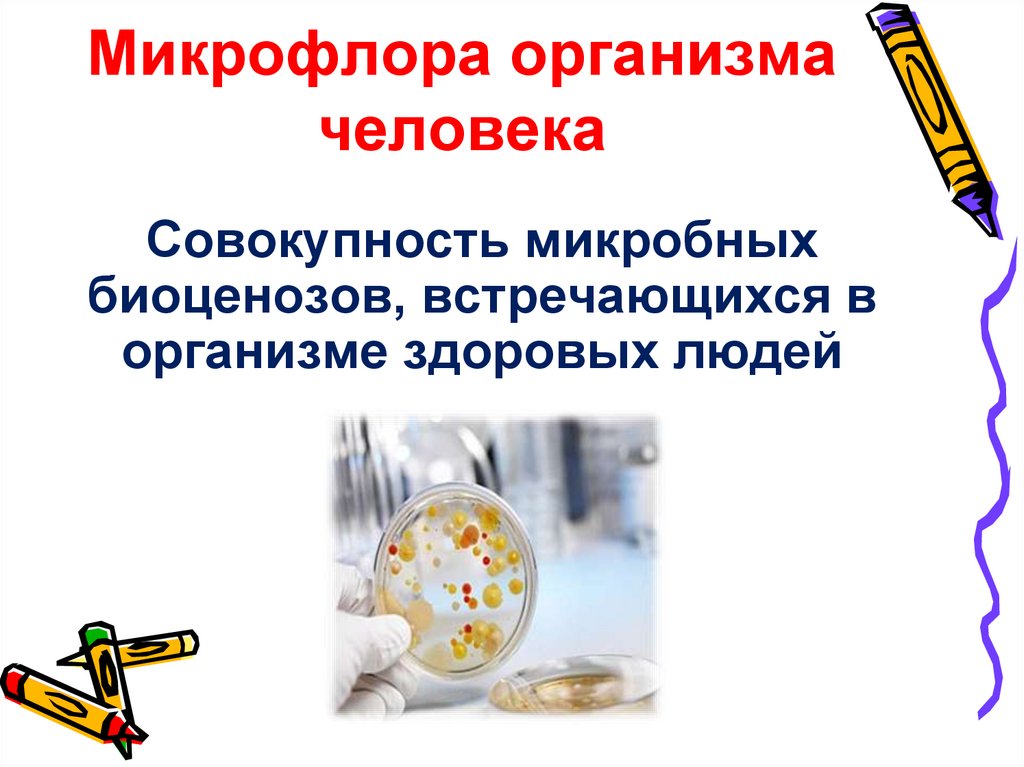
Микрофлора организма человека

Похожие презентации:
тема_1_6_Микрофлора_организма_человека_к_лекции
1. Микрофлора организма человека
2. Микрофлора организма человека
Совокупность микробныхбиоценозов, встречающихся в
организме здоровых людей
3.
4.
Нормальная микрофлора отдельных биотопов(биотоп – место обитания) различна, но
подчиняется ряду основных
закономерностей:
достаточно стабильна;
образует биопленку;
представлена несколькими видами, среди
которых выделяют доминантные виды и
виды-наполнители;
преобладающими являются
анаэробные бактерии.
5.
Состав нормальноймикрофлоры может меняться
в зависимости от:
• возраста
• условий внешней среды
• условий труда
• рациона питания
• перенесенных заболеваний
• травм и стрессовых ситуаций
6. Классификация микрофлоры
Все многообразие микробов,встречающихся в организме человека,
можно разделить на две группы
Резидентная
микрофлора
Транзиторная
микрофлора
представлена относительно
попадает на кожу или слизистые
стабильным составом
оболочки из окружающей среды, не
микроорганизмов, обычно
вызывая заболеваний и не обитая
обнаруживаемых в определенных
постоянно на поверхностях тела
местах тела человека у людей
человека
определенного возраста
7. Основные биотопы организма
Заселяемые биотопы – в этих биотопахбактерии живут, размножаются и
выполняют определенные функции.
Стерильные биотопы – в этих биотопах
в норме бактерии отсутствуют.
8. Заселяемые биотопы
КожаВоздухоносные пути
ЖКТ
Наружные половые органы, уретра
Наружный слуховой проход
Конъюнктива
9.
Формирование микрофлорыначинается с рождения и зависит от:
1.Вида родов (попадание микробов на кожу и слизистые
новорожденного)
2.Типа вскармливания (грудное, искусственное)
3.Состояния здоровья матери
и медперсонала
4.Санитарного состояния
объектов окружающей среды
10. Отрицательное влияние микрофлоры на организм человека
Условно-патогенные представителинормальной микрофлоры могут стать
источником эндогенной инфекции
Под влиянием микрофлоры может
увеличиваться выделение гистамина
– аллергические состояния
11. Микрофлора кожных покровов
12.
Микрофлора кожи - полезныемикроорганизмы, наши постоянные
«сожители» прекрасно приспособлены к
родной среде и помогают поддерживать
биологическую стабильность,
чистоту кожи и защищают ее от
патогенных микроорганизмов.
Микрофлора здоровой кожи - это
достаточно устойчивая к внешним
воздействиям экосистема.
13.
Состав микрофлоры кожиВ составе резидентной микрофлоры кожи
и слизистых оболочек присутствуют:
Эпидермальный стафилококк
Стафилококк золотистый
Микрококки
Сарцины
Коринеформные бактерии
14.
Состав микрофлоры кожи различается в разныханатомических зонах в зависимости от:
Содержания кислорода
в
окружающей бактерии
среде (аэробы —
анаэробы)
Близости к слизистым
оболочкам (рот, нос,
перианальная
область), особенностей
секреции и даже
одежды человека
15. Наиболее заселенные микроорганизмами зоны
• подмышечные впадины• межпальцевые промежутки
• паховые складки
• промежность
16.
17. Бактериальные и грибковые заболевания кожи
АкнеКандидоз
Дерматомикозы
18. Грибковые заболевания кожи головы
Фавусзаболевание , при котором
страдает кожа волосистой
части головы. Заразиться
можно при пользовании
предметами личной гигиены
больного (расческа, заколка)
Микроспория
грибковое заболевание,
поражаются кожа и
волосы, иногда ногтевые
пластинки.
Стригущий лишай
грибковое заболевание,
поражается кожа головы, может быть
поверхностным и глубоким.
19.
Профилактика заболеваний• необходимо исключить
использование предметов
личной гигиены другими
людьми;
• важно научить детей не
подходить к чужим и тем
более бездомным животным;
• не стоит примерять чужие
головные уборы или одежду;
• при возвращении с улицы
нужно сразу же мыть руки;
• укреплять иммунитет
20. Микрофлора желудочно-кишечного тракта
21. Микрофлора ЖКТ – совокупность микроорганизмов, находящихся в просвете ЖКТ.
ПолезнаяБолезнетворная
22. Функции микрофлоры
ЗащитнаяФерментативная
Синтез витаминов
Синтез белков и аминокислот
Обмен микроэлементов
Иммунная
23.
24. Микрофлора ротовой полости
25. Микроорганизмы начинают заселять полость рта с момента рождения человека при его первом вдохе
26.
Микрофлора полости ртаОбеспечивает колонизационную
резистентность организма и оказывает
положительное влияние на иммунную систему
2.
Выступает в качестве основного поставщика
возбудителей инфекций
1.
27. Факторы, благоприятствующие развитию микроорганизмов в ротовой полости
• достаточно большоеколичество питательных
веществ
• оптимальная температура
• щелочная реакция среды
• достаточная влажность
28. Полость рта населена обильной и разнообразной микрофлорой, которая попадает в нее из окружающей среды с воздухом, водой, пылью
и продуктамипитания
29. В микрофлоре полости рта может насчитываться от 150 до 300 видов бактерий
30. Микрофлора полости рта включает 1.Грибы 2.Вирусы 3.Простейшие организмы 4.Бактерии Из бактерий примерно 80-90% составляют кокки
различных видов.31.
Микрофлора полости рта32. Факторы, влияющие на состав микрофлоры
• Состав слюны• Консистенция и характер
пищи
• Гигиеническое содержание
ротовой полости
• Состояние тканей и
органов ротовой полости
• Наличие соматических
заболеваний
• Прием антибиотиков
• Наличие зубных протезов
33.
КариесКандидоз
Streptococcus mutans
грибы рода Кандида
34. Стоматит
вирусыгрибки рода Кандида
стафилококки
стрептококки
Пародонтит
грамположительные кокки
(стрептококки)
грамотрицательные кокки
нитевидные формы
факультативные
анаэробные палочки
35. Микрофлора пищевода
36.
У здоровых людеймикрофлора
пищевода
достаточно скудная,
состоит из
микроорганизмов,
поступающих со
слюной и пищей
37. Микрофлора желудка
38.
Фактор,благоприятствующий заселению МО
Нарушение кислотности желудочного сока
39.
Микрофлора :• Вейлонеллы
• Нейссерии
• Стрептококки
• Бактероиды полости рта
• Лактобактерии
• Микрококки
• Различные грибы
40. Заболевания, вызванные дисбиозом желудка
• Язвеннаяболезнь
• Гастрит
• Гастроэнтерит
• Рак
41. Микрофлора кишечника
42.
Формирование микрофлорыкишечника
43.
44. Микрофлора тонкого кишечника
В двенадцатиперстной кишке не содержитсямикроорганизмов из-за действия
дуоденального сока.
В проксимальном отделе тонкого кишечника
микроорганизмы либо отсутствуют, либо
присутствуют в мизерном количестве и
исчезают после прохождения комка пищи.
В основном микрофлора присутствует в
дистальной части подвздошной кишки.
45.
Микрофлора:• Лактобактерии
• Кокки
• Бифидобактерии
• Бактероиды
46. Микрофлора толстого кишечника
Факторы, способствующие заселению МО:• Нерегулярное опорожнение
• Запор
47. Микрофлора
бактероиды
бифидобактерии
энтерококки
клостридии
эубактерии
энтеробактерии
стрептококки
стафилококки
лактобактерии
грибы
48. Факторы, способствующие избыточному росту флоры кишечника
наличие свищей в кишечнике;хирургические операции;
атрофический гастрит;
применение лекарственных препаратов,
особенно антибиотиков, которые убивают как
патогенную, так и полезную микрофлору;
нарушение моторики кишечника;
непроходимость кишечника
49. Нарушение баланса полезных и патогенных бактерий приводит к дисбактериозу и другим заболеваниям
50. Болезни, вызываемые кишечными бактериями
сальмонеллезы
брюшной тиф и паратифы А и В
пищевая токсикоинфекция
дизентерия (шигиллез)
эшерихиоз
клебсиеллез
бруцеллез
холера
туляремия
51. Дисбактериоз
– качественные и количественные изменениямикрофлоры.
Дисбактериоз сопровождается снижением
облигатной анаэробной флоры (бифидо- и
лактобактерии) и увеличением условно –
патогенной микрофлоры.
52. Факторы, способствующие развитию дисбактериоза
• инфекционные заболевания органов пищеварения• заболевания ЖКТ, печени, онкологическая
патология
• аллергические заболевания
• прием антибиотиков, гормонов,
иммунодепрессантов, цитостатиков, психотропных,
слабительных и противозачаточных препаратов
• воздействие на организм промышленных ядов и
пестицидов
• сезон года, питание человека, стрессы, курение,
наркомания, алкоголизм.
53. Профилактика дисбактериоза
• организация сбалансированного меню ирационального режима питания
• контроль над приемом антибиотиков
• своевременное и правильное лечение
хронических заболеваний органов
пищеварения
• избегание психических расстройств и
перенапряжений, а также негативного
воздействия факторов окружающей среды
54. Микрофлора дыхательных путей
55. Представители микрофлоры носовой полости
НейссерииКоагулазоотрицательные
стафилококки
Коринебактерии
(дифтероиды)
Альфа-гемолитические
стрептококки
56. Транзиторные представители микрофлоры носовой полости
кишечнаяпалочка
золотистый
стафилококк
бетагемолитический
стрептококк
57. Представители микрофлоры зева
ЭнтерококкиМоракселлы
Микоплазмы
Актиномицеты
58.
БактероидыБетагемолитические
стрептококки
Пневмококки
59. Носоглотка
• Стрептококки (до 80-90%)• Бактероиды
• Нейссерии
• Вейлонеллы и др.
Факультативная микрофлора
• условно-патогенные
• патогенныебактерии
• микобактерии
60. Миндалины
• Стрептококки• Стафилококки
• Коринебактерии
Иногда :
• Энтеробактерии
• Синегнойная палочка
• Фузобактерии
• Спириллы
• Вибрионы
61. Нижние отделы дыхательных путей
Слизистая оболочка гортани,трахеи, бронхов и всех
нижележащих
отделов
сохраняется
стерильной
благодаря активности их
эпителия,
макрофагов,
а
также
продукции
секреторного
иммуноглобулина А.
62.
ЗаболеванияПневмония
63.
ФарингитСкарлатина
64. Микрофлора слизистой оболочки глаз
65.
В нормальной микрофлоре глаза(конъюнктивы) доминирующими
микроорганизмами на слизистых
оболочках глаза являются:
• дифтероиды (коринеформные бактерии);
• нейссерии;
• грамотрицательные бактерии,
преимущественно рода Moraxella
Нередко обнаруживаются:
• стафилококки;
• стрептококки;
• микоплазмы.
66.
Передняя камера глаза, глазницаи внутренняя среда глазного
яблока стерильны
67.
Это – полиэтиологическое воспалительноепоражение конъюнктивы – слизистой
оболочки, покрывающей внутреннюю
поверхность век и склеру.
68. Микрофлора мочеполового тракта
69.
Видовой составнормальной
микрофлоры
разнообразен:
сапрофиты и
паразиты
Взаимоотношения
: конкуренция,
синергизм,
нейтрализм
70. Микрофлора уретры здоровых мужчин
эпидермальныйстафилококк
гноеродный или
золотистый
стафилококк
бактерии рода
коринебактерий
71.
Микрофлора влагалищапалочка Додерлейна
стафилококки,
лактобактерии,
коринебактерии,
кишечная палочка
стрептококки

Биология
Биология








